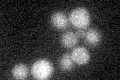
YER136W
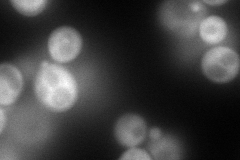
YER136W
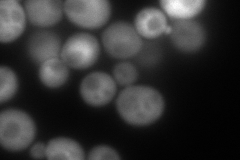
YER136W
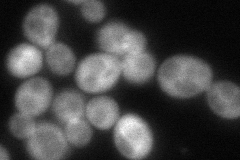
YER136W
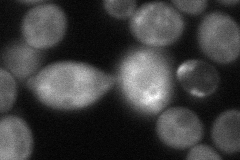
YER136W

View description
GDP dissociation inhibitor, regulates vesicle traffic in secretory pathways by regulating the dissociation of GDP from the Sec4/Ypt/rab family of GTP binding proteins
Localization:
Intensity:
Fold change:
Significance:
-
C’ GFP library in SD
below threshold15.25 -
N' NOP1pr-GFP in SD
cytosol193.666 -
N' TEF2pr-mCherry in SD
cytosol260.564 -
N' NATIVEpr-GFP in SD
cytosol99.8553 -
N' TEF2pr-VC and Cyto-VN in SD
cytosol68.5894 -
C’ GFP library in SD+DTT

cytosol14.120.92No -
C’ GFP library in SD+H2O2

cytosol14.720.96No -
C’ GFP library in Starvation Media

cytosol17.051.11No -
C’ GFP library on the background of Pup2-DaMP

below threshold -
C’ GFP library on the background of CCT mutant

below threshold14.72280.965313No
